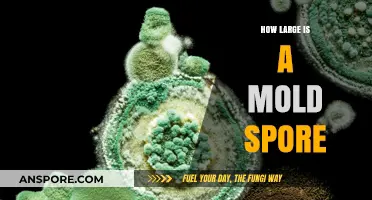
Understanding Mold Spore Size: Microscopic Dimensions and Their Impact

Coccidia spores, also known as oocysts, are highly resilient structures produced by coccidian parasites, which can infect a variety of animals, including pets and livestock. One of the most critical aspects of managing coccidiosis, the disease caused by these parasites, is understanding the longevity of their spores in the environment. Coccidia spores can survive for extended periods, often ranging from several weeks to months, depending on environmental conditions such as temperature, humidity, and sunlight exposure. This durability allows them to persist in soil, water, and other surfaces, posing a continuous risk of infection to susceptible hosts. Knowing how long coccidia spores last is essential for implementing effective sanitation and prevention strategies to control outbreaks and protect animal health.
| Characteristics | Values |
|---|---|
| Survival in Environment | Coccidia spores (oocysts) can survive in the environment for 1-4 years under favorable conditions (moisture, moderate temperature). |
| Temperature Resistance | Tolerant to freezing temperatures and can survive in cold climates. |
| Desiccation Tolerance | Can survive desiccation (drying) for extended periods, though survival time decreases in dry conditions. |
| Disinfectant Resistance | Resistant to many common disinfectants; requires specialized cleaners (e.g., bleach diluted 1:32) for effective removal. |
| pH Tolerance | Survives in a wide pH range, from slightly acidic to slightly alkaline environments. |
| Humidity Requirement | Requires moisture to remain viable; survival decreases in low-humidity environments. |
| Sunlight Sensitivity | UV light from sunlight can reduce spore viability over time, but they can still survive in shaded areas. |
| Host Dependency | Does not require a host to survive but needs a host (e.g., animals) to complete its life cycle. |
| Species Variation | Survival duration may vary slightly between different species of coccidia. |
| Indoor vs. Outdoor Survival | Survives longer indoors (e.g., in kennels, barns) due to controlled moisture and temperature. |
Explore related products
$53.95
What You'll Learn
- Environmental Factors Affecting Spores: Temperature, humidity, and sunlight impact coccidia spore survival duration significantly
- Surface Type Influence: Spores last longer on porous surfaces like soil compared to smooth materials
- Disinfection Methods: Effective cleaning agents reduce spore lifespan, ensuring quicker elimination from environments
- Indoor vs. Outdoor Survival: Spores persist longer indoors due to controlled conditions, shorter outdoors with exposure
- Species-Specific Durations: Different coccidia species have varying spore lifespans, ranging from weeks to years

Environmental Factors Affecting Spores: Temperature, humidity, and sunlight impact coccidia spore survival duration significantly
Coccidia spores, the resilient forms of this parasitic protozoan, can persist in the environment for months, posing a persistent threat to susceptible animals. However, their survival is not absolute; environmental factors play a critical role in determining how long these spores remain viable. Among these, temperature, humidity, and sunlight emerge as key influencers, each exerting a unique effect on spore longevity.
Understanding these factors is crucial for implementing effective control measures in environments where coccidia is a concern, such as farms, kennels, and pet shelters.
Temperature: Coccidia spores exhibit a clear preference for moderate temperatures. Studies suggest optimal survival occurs between 15°C and 25°C (59°F and 77°F). At temperatures below 10°C (50°F), spore viability decreases significantly, while temperatures exceeding 30°C (86°F) can accelerate their demise. This knowledge can be practically applied by adjusting housing temperatures for susceptible animals, particularly during colder months, to minimize spore survival.
For example, maintaining kennel temperatures above 10°C can help reduce the risk of coccidiosis outbreaks.
Humidity: Moisture is a double-edged sword for coccidia spores. While they require some moisture to remain viable, excessive humidity can promote the growth of fungi and bacteria that compete with the spores for resources, ultimately leading to their decline. Ideally, coccidia spores thrive in environments with relative humidity levels between 50% and 70%. In areas with high humidity, ensuring proper ventilation and using dehumidifiers can help create an environment less conducive to spore survival.
Conversely, in arid climates, providing adequate hydration for animals and potentially increasing ambient humidity within controlled environments can be beneficial.
Sunlight: Ultraviolet (UV) radiation from sunlight acts as a natural disinfectant, effectively destroying coccidia spores. Direct sunlight exposure for as little as 30 minutes can significantly reduce spore viability. This highlights the importance of sunlight exposure in outdoor environments. Regularly cleaning and disinfecting areas where animals congregate, followed by exposure to direct sunlight, can be a powerful tool in coccidia control.
By understanding the interplay of temperature, humidity, and sunlight, we can strategically manipulate environmental conditions to minimize the survival of coccidia spores. This knowledge empowers us to create safer and healthier environments for animals susceptible to this parasitic infection.
Effective Milky Spore Application: A Step-by-Step Guide for Lawn Grub Control
You may want to see also

Surface Type Influence: Spores last longer on porous surfaces like soil compared to smooth materials
Coccidia spores, the resilient cysts shed by infected animals, exhibit a striking survival disparity based on the surface they inhabit. Porous materials like soil, carpet, or unsealed wood provide an ideal environment for these spores to persist, often remaining viable for up to a year or more. This longevity stems from the protective nooks and crannies within these surfaces, shielding spores from environmental stressors like sunlight, desiccation, and disinfectants. In contrast, smooth, non-porous surfaces such as tile, metal, or sealed concrete offer little refuge, with spores typically surviving only a matter of days to weeks.
Understanding this surface-dependent survival is crucial for effective coccidia control, particularly in environments housing susceptible animals like puppies, kittens, or immunocompromised pets.
Consider a scenario where a kennel floor is contaminated with coccidia spores. If the floor is made of porous concrete, routine cleaning with water and mild detergent may not suffice. Spores embedded within the surface’s microscopic crevices can continue to infect animals long after visible signs of contamination are gone. In such cases, a two-pronged approach is necessary: mechanical removal of debris through scrubbing, followed by application of a coccidia-specific disinfectant like diluted bleach (1:32 ratio) or accelerated hydrogen peroxide. For smooth surfaces like stainless steel feeding bowls, a simpler protocol—washing with hot, soapy water and rinsing thoroughly—is often sufficient to eliminate spores.
The age and health status of exposed animals further complicates surface management. Young animals under six months, whose immune systems are still developing, are particularly vulnerable to coccidia infection. In such cases, prioritizing smooth, easily disinfected surfaces in their living areas can significantly reduce transmission risk. For outdoor environments where porous soil is unavoidable, implementing designated play areas with sand or gravel (which can be periodically replaced) offers a practical compromise, minimizing direct contact with potentially contaminated ground.
A comparative analysis of surface types reveals a clear hierarchy of risk. Porous surfaces act as reservoirs, demanding aggressive cleaning protocols and potentially requiring material replacement in severe cases. Semi-porous surfaces like linoleum or sealed grout present an intermediate challenge, necessitating regular deep cleaning with appropriate disinfectants. Smooth surfaces, while not immune to contamination, offer the most manageable scenario, allowing for effective disinfection with standard cleaning practices. This hierarchy should guide material selection in animal care facilities, prioritizing smooth, non-porous options wherever feasible.
Ultimately, the surface type’s influence on coccidia spore survival underscores the importance of tailored environmental management. By understanding how spores interact with different materials, caregivers can implement targeted strategies to break the cycle of infection. This includes selecting appropriate surface materials, employing surface-specific cleaning protocols, and considering the unique vulnerabilities of the animals in their care. While complete eradication of coccidia spores from all surfaces is impractical, strategic surface management can dramatically reduce their impact, safeguarding animal health and well-being.
How Do Birds Nest Ferns Reproduce? Unveiling Their Spore-Based Life Cycle
You may want to see also

Disinfection Methods: Effective cleaning agents reduce spore lifespan, ensuring quicker elimination from environments
Coccidia spores, known for their resilience, can survive in the environment for months, posing a persistent threat to animal and human health. However, the lifespan of these spores can be significantly reduced through targeted disinfection methods. Effective cleaning agents not only kill the spores but also disrupt their protective structures, ensuring quicker elimination from contaminated surfaces. This dual action is critical for breaking the cycle of infection in homes, farms, and veterinary settings.
Analytical Insight: The key to combating coccidia spores lies in understanding their resistance mechanisms. These spores are encased in a robust outer layer that shields them from environmental stressors and many common disinfectants. However, agents like chlorine bleach (sodium hypochlorite) at a concentration of 1:32 dilution (approximately 0.5% solution) have proven effective in breaking down this protective barrier. Studies show that a 10-minute contact time with this solution can reduce spore viability by over 99%. Similarly, accelerated hydrogen peroxide (AHP) at a 0.5% concentration achieves comparable results, making it a safer alternative for environments where chlorine bleach may cause corrosion or irritation.
Instructive Steps: To effectively disinfect surfaces contaminated with coccidia spores, follow these steps: 1) Remove organic debris from the area, as it can shield spores from disinfectants. 2) Apply the chosen cleaning agent (e.g., bleach or AHP) at the recommended concentration, ensuring even coverage. 3) Allow the disinfectant to remain on the surface for the specified contact time—typically 10–20 minutes. 4) Rinse or wipe the area thoroughly, especially in environments where animals or children are present, to prevent ingestion of residual chemicals. For high-risk areas like kennels or barns, repeat the process daily until the risk of infection is mitigated.
Comparative Perspective: While chlorine bleach and AHP are highly effective, other disinfectants like quaternary ammonium compounds (quats) and phenolic compounds offer varying degrees of success. Quats, commonly found in household cleaners, are less effective against coccidia spores due to their inability to penetrate the spore’s outer layer. Phenolic compounds, though more potent, require longer contact times (up to 30 minutes) and are less practical for routine use. For environments where chemical disinfectants are undesirable, steam cleaning at temperatures above 176°F (80°C) for at least 5 minutes can also destroy spores, though this method is less precise and may damage certain surfaces.
Practical Tips: When selecting a disinfection method, consider the environment and its inhabitants. For example, in households with pets, avoid using bleach in areas where animals may lick surfaces; opt for pet-safe alternatives like AHP or steam cleaning. In agricultural settings, rotate disinfectants periodically to prevent the development of resistant strains. Additionally, always wear protective gear, such as gloves and goggles, when handling concentrated disinfectants. Proper ventilation is equally important to avoid inhalation of fumes, particularly in enclosed spaces like barns or shelters.
How Spores Enable Fungi to Disperse and Colonize New Environments
You may want to see also
Explore related products

Indoor vs. Outdoor Survival: Spores persist longer indoors due to controlled conditions, shorter outdoors with exposure
Coccidia spores, the resilient cysts shed by infected animals, pose a persistent threat due to their ability to survive in various environments. Their longevity differs dramatically between indoor and outdoor settings, influenced by factors like temperature, humidity, and exposure to elements.
Understanding this disparity is crucial for implementing effective disinfection strategies and preventing coccidiosis outbreaks.
Indoor environments, with their controlled temperatures, stable humidity levels, and lack of direct sunlight, provide an ideal haven for coccidia spores. Studies suggest they can remain viable for months to years on surfaces like carpet, upholstery, and even hard floors if not thoroughly cleaned. This extended survival time highlights the importance of rigorous disinfection protocols in homes with pets, particularly puppies and kittens, who are highly susceptible to coccidiosis.
Regular cleaning with dilute bleach solutions (1:32 ratio of bleach to water) or specialized disinfectants labeled effective against coccidia is essential. Focus on areas frequented by pets, including bedding, feeding areas, and litter boxes.
In contrast, outdoor environments present a harsher reality for coccidia spores. Exposure to sunlight, fluctuating temperatures, and precipitation significantly reduces their survival time. Direct sunlight, with its UV rays, acts as a natural disinfectant, rapidly degrading the spore's structure. Rainfall can wash away spores, diluting their concentration and hindering their ability to infect new hosts. While complete eradication outdoors is challenging, the natural elements contribute to a shorter survival time, often measured in weeks rather than months.
This disparity in survival times underscores the importance of a multi-pronged approach to coccidiosis prevention. While outdoor environments offer some natural protection, diligent cleaning and disinfection remain crucial, especially in areas where infected animals have access. For indoor spaces, a more aggressive and consistent disinfection regimen is necessary to combat the prolonged survival of spores.
Teaching Breloom Spore: Strategies and Tips for Effective Training
You may want to see also

Species-Specific Durations: Different coccidia species have varying spore lifespans, ranging from weeks to years
Coccidia, a group of microscopic parasites, exhibit remarkable diversity in their spore lifespans, which can range from mere weeks to several years. This variability is not random but is deeply rooted in the biology and ecology of each species. For instance, *Isospora* species, commonly affecting birds and mammals, typically produce spores that remain viable for several weeks to months under favorable conditions. In contrast, *Cryptosporidium* and *Toxoplasma gondii*, which can infect a broader range of hosts, including humans, often produce spores (oocysts) that can persist in the environment for up to a year or more. Understanding these species-specific durations is crucial for implementing effective control measures, as the longevity of spores directly impacts the risk of transmission and the design of disinfection protocols.
Consider the practical implications of these differences in a veterinary or agricultural setting. For *Eimeria* species, which primarily infect poultry and livestock, spores can survive in soil and litter for several months, especially in humid and temperate climates. This extended viability necessitates rigorous cleaning and disinfection routines, such as removing contaminated bedding and using ammonia-based cleaners to break down oocyst walls. In contrast, *Cryptosporidium* spores are highly resistant to chlorine disinfection, requiring specialized methods like UV treatment or filtration to eliminate them from water sources. Tailoring control strategies to the specific coccidia species involved ensures more effective prevention of outbreaks and reduces economic losses in animal production.
From a public health perspective, the longevity of coccidia spores underscores the importance of species-specific risk assessments. *Toxoplasma gondii*, for example, can remain infectious in soil for over a year, posing a significant risk to pregnant women and immunocompromised individuals through contact with contaminated cat feces or unwashed produce. Public health campaigns should emphasize behaviors such as wearing gloves while gardening, washing hands after handling soil, and thoroughly cleaning fruits and vegetables. Similarly, water treatment facilities must account for the chlorine resistance of *Cryptosporidium* spores, which have caused large-scale outbreaks in drinking water systems. By focusing on the unique characteristics of each coccidia species, public health interventions can be more targeted and effective.
A comparative analysis of coccidia spore lifespans reveals how environmental factors interact with species-specific traits to influence viability. For example, *Sarcocystis* spores, which can infect both intermediate and definitive hosts, often survive longer in cooler, shaded environments, whereas *Cyclospora* spores thrive in warm, humid conditions. This highlights the need for context-specific management practices. In tropical regions, where *Cyclospora* is endemic, water sanitation efforts must prioritize methods that target heat-resistant spores, such as advanced filtration or ozonation. Conversely, in temperate climates, controlling *Sarcocystis* may involve reducing shaded areas where spores can persist. Such tailored approaches demonstrate how understanding species-specific durations can lead to more efficient and sustainable control measures.
Finally, the variability in coccidia spore lifespans has significant implications for research and diagnostics. Laboratories must employ species-specific testing methods to accurately detect and quantify spores in environmental samples. For instance, PCR-based assays are often used to identify *Cryptosporidium* and *Giardia* due to their high sensitivity and specificity, while microscopy remains a standard tool for detecting *Eimeria* oocysts in fecal samples. Researchers studying coccidia transmission dynamics must also account for spore longevity when designing experiments, as the persistence of spores can confound results if not properly controlled. By acknowledging and addressing these species-specific differences, scientists can advance our understanding of coccidia biology and develop more effective interventions to mitigate their impact on health and agriculture.
Rubbing Alcohol vs. Fungus Spores: Effective Treatment or Myth?
You may want to see also
Frequently asked questions
Coccidia spores, known as oocysts, can survive in the environment for several months to over a year, depending on conditions such as temperature, humidity, and sunlight exposure.
Coccidia spores are more resistant to heat than cold, but extreme heat (above 122°F or 50°C) can kill them. However, they can still survive in hot environments for extended periods if protected from direct sunlight.
Yes, coccidia spores can survive in cold temperatures, including freezing conditions, for several months to a year, making them resilient in winter environments.
Coccidia spores can remain infectious on surfaces like kennels, bedding, or soil for weeks to months, especially in damp and shaded areas, posing a risk to susceptible animals.
Most disinfectants do not kill coccidia spores immediately. Specialized cleaners containing ammonia or steam cleaning at high temperatures (above 160°F or 71°C) are needed to effectively eliminate them.